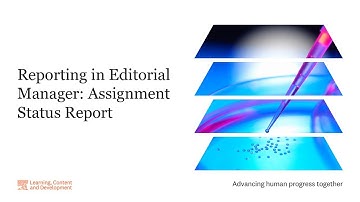
Reporting in Editorial Manager: Assignment Status Report

⬇ DOWNLOAD NOW
Jika muncul iklan pop-up, tutup lalu klik tombol kembali
Download lagu Reporting in Editorial Manager: Editor Performance Report secara gratis hanya untuk keperluan promosi. Dukung artis favorit kamu dengan membeli musik original di iTunes atau platform resmi lainnya.
 Reporting in Editorial Manager: Reviewer Performance Report
Reporting in Editorial Manager: Reviewer Performance Report Reporting in Editorial Manager: Journal Accountability Report
Reporting in Editorial Manager: Journal Accountability Report Reporting in Editorial Manager: Assignment Status Report
Reporting in Editorial Manager: Assignment Status Report Python in Excel‼️ #excel #python
Python in Excel‼️ #excel #python Reports writing English
Reports writing English Salesforce 101: Report Filters
Salesforce 101: Report Filters Respect for IIT Bombay 📉📉📉 | IIT Status #jee2025 #iitbombay #iit
Respect for IIT Bombay 📉📉📉 | IIT Status #jee2025 #iitbombay #iit How to make a Pivot Table in 3 Steps‼️ #excel
How to make a Pivot Table in 3 Steps‼️ #excel